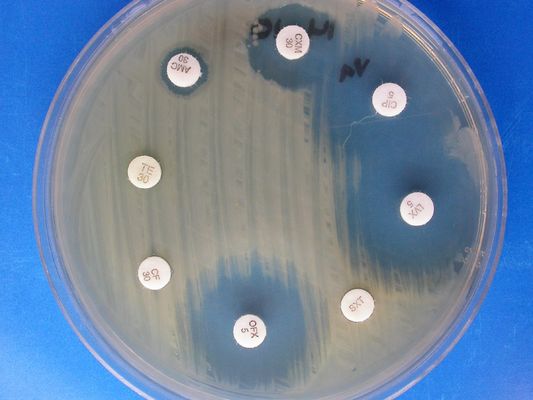
产品封面图

万千商家帮你免费找货
0 人在求购买到急需产品
- 详细信息
- 文献和实验
- 技术资料
- 库存:
1000
- 供应商:
青岛捷世康
- 英文名:
0
- 规格:
10ml*20支/盒
产设备。与国内国际著名实验室保持良好的合作与交流。致力于生产稳定高效的产品以及提供优质的服务。生
产产品及代理品牌产品范围涵盖了分子生物学、细胞生物学、细菌学、遗传学、免疫学、生物化学、蛋白质学
等生命科学相关领域及相关实验室消耗品。
产品名称:蔗糖
产品规格:10ml*20支/盒
产品编号:BS3061
配制培养基的原则:
培养基中营养物质浓度合适时微生物这样才能生长良好,营养物质浓度过低的时候不能满足微生物正常生长需
要,浓度过高时则可能对微生物生长起抑制作用,高浓度糖类物质、无机盐、重金属离子等不仅不能维持和促
进微生物的生长,反而起到抑菌或杀菌作用,培养基中各营养物质之间的浓度配比也直接影响微生物的生长繁
殖和代谢产物的形成和积累。
公司其他优势产品:
1/4MS培养基 用于植物组织培养
B5培养基 用于植物组织培养
N6培养基 用于植物组织培养
NLN培养基 用于植物组织培养
DMEM(高葡萄糖) 含4500mg/L D-葡萄糖和L-谷氨酰胺?,不含碳酸氢钠
DMEM(高葡萄糖) 含4500mg/L D-葡萄糖和L-谷氨酰胺?,不含酚红、丙酮酸钠和碳酸氢钠
DMEM(高葡萄糖) 含4500mg/L D-葡萄糖、L-谷氨酰胺和25mM HEPES,不含丙酮酸钠和碳酸
氢钠
MT培养基 用于植物组织的培养
C81V培养基 用于植物组织培养
改良MS-H培养基 用于植物组织培养
knudson C 培养基 用于兰花组织培养
DMEM(低葡萄糖) 含1000mg/L D-葡萄糖、L-谷氨酰胺和110mg/L丙酮酸钠,不含碳酸氢钠
风险提示:丁香通仅作为第三方平台,为商家信息发布提供平台空间。用户咨询产品时请注意保护个人信息及财产安全,合理判断,谨慎选购商品,商家和用户对交易行为负责。对于医疗器械类产品,请先查证核实企业经营资质和医疗器械产品注册证情况。
 文献和实验
文献和实验蔗糖 saccharose 亦称甜菜糖、α- D- 葡萄吡喃糖 - β -D- 果糖呋喃糖苷、或β -D- 果糖呋喃糖 - α -D- 葡糖吡喃糖苷。在具有光合成能力的所有植物中均可见到。工业上主要是用甘蔗、甜菜来生产。可由酵母进行非还原性发酵。在稀酸或蔗糖酶的作用下水解时可变成 D- 葡萄糖和 D- 果糖的等量混合物(比旋光度 [ α ] D = - 20 °),也就是说变成了转化糖。因为旋光性以右旋逆转为左旋,所以将此反应称为转化。蔗糖在肠粘膜细胞中的麦芽糖酶Ⅲ或Ⅳ的作用
砂糖是一种应用广泛的甜味料。含砂糖的植物不少,用作制糖原料的主要是甘蔗和甜菜。甘蔗产于热带、亚热带,其茎中含糖量为10~20%。甜菜在寒冷地区栽培,其根中含糖量亦为10~20%。世界上砂糖的产量约65%来自甘蔗,只有约35%取自甜菜,所以砂糖也称蔗糖。 此外,在加拿大将野生的、含有糖的枫树液(含糖量约2%),浓缩成糖汁制成枫树糖,用以制作烤饼。而在热带、温带地区,有将含有糖的椰子树液(含糖量约10%)浓缩制成椰子糖,也有将含有糖的高粱茎(含糖量为10~18%)作为原料,制成
蔗糖酶 sucrase 将蔗糖水解成 D-果糖和 D-葡萄糖的β-D-果糖苷酶的一种,又称为转化酶(invertase)或蔗糖酶(saccharase) EC 3.2.1.26。除广泛分布于微生物、植物外,类似的活性也在动物的消化液中发现,从链孢霉提纯获得的酶除作用蔗糖外,还可作用具有β-呋喃果糖苷键的物质。例如棉子糖、水苏糖等的寡糖,尤其也能同样地作用具有作为糖苷配基的甲基等的烷基、苯基等丙烯基的配糖体。一般微生物的蔗糖酶也催化从蔗糖将β-果糖苷基转移到其他糖、醇、酚上的反应
 技术资料
技术资料暂无技术资料 索取技术资料